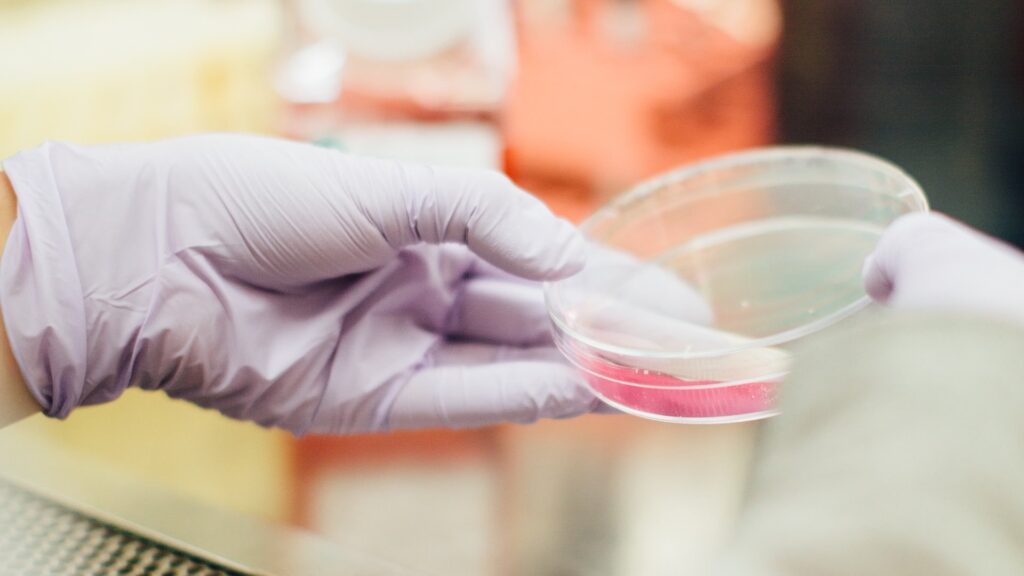

Ученые объявили о новом открытии: они назвали вирус, который может вызывать рак крови. Об этом сообщает Bizmedia.kz.
Риск развития множественной миеломы после лечения гепатита может возрастать из-за воздействия гепатита на организм. Множественная миелома характеризуется образованием аномальных клеток, которые выполняют важную функцию — защищают организм от инфекций. Это было подтверждено исследованием, результаты которого опубликованы в медицинском журнале Haematologica.
В исследовании приняли участие 54 пациента с гепатитами В и С, у всех из которых была выявлена моноклональная гаммапатия — частое предшественника множественной миеломы. Анализ организма пациентов показал наличие большого количества антител, направленных на борьбу с вирусом гепатита. Исследование пациентов с множественной миеломой, инфицированных гепатитом В и С, показало, что антивирусная терапия повышает шансы на выживание. В связи с этим рекомендуется начинать антивирусное лечение людям с гепатитом В или С как можно раньше.
Кроме того, важно предотвращать эти инфекции у лиц с моноклональной гаммапатией, чтобы предотвратить развитие злокачественных опухолей.